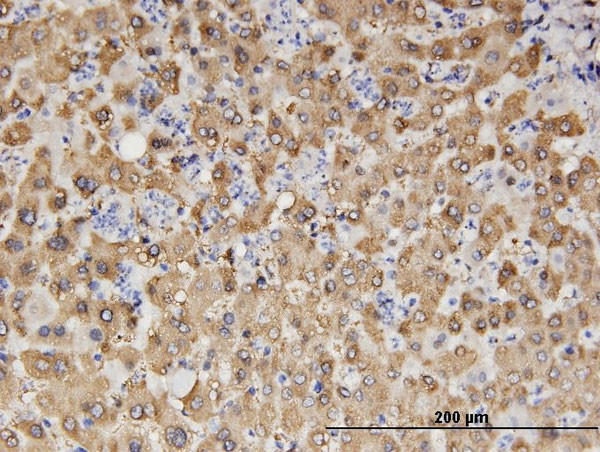
ALDH1A1 Antibody in Immunohistochemistry (Paraffin) (IHC (P))

Search
Abnova
ALDH1A1 Monoclonal Antibody (1G6)
{{$productOrderCtrl.translations['antibody.pdp.commerceCard.promotion.promotions']}}
{{$productOrderCtrl.translations['antibody.pdp.commerceCard.promotion.viewpromo']}}
{{$productOrderCtrl.translations['antibody.pdp.commerceCard.promotion.promocode']}}: {{promo.promoCode}} {{promo.promoTitle}} {{promo.promoDescription}}. {{$productOrderCtrl.translations['antibody.pdp.commerceCard.promotion.learnmore']}}
产品信息
H00000216-M05
宿主/亚型
分类
类型
克隆号
抗原
偶联物
形式
浓度
规格
保存条件
运输条件
产品详细信息
Sequence of this protein is as follows: MSSSGTPDLP VLLTDLKIQY TKIFINNEWH DSVSGKKFPV FNPATEEELC QVEEGDKEDV DKAVKAARQA FQIGSPWRTM DASERGRLLY KLADLIERDR LLLATMESMN GGKLYSNAYL NDLAGCIKTL RYCAGWADKI QGRTIPIDGN FFTYTRHEPI GVCGQIIPWN FPLVMLIWKI GPALSCGNTV VVKPAEQTPL TALHVASLIK EAGFPPGVVN IVPGYGPTAG AAISSHMDID KVAFTGSTEV GKLIKEAAGK SNLKRVTLEL GGKSPCIVLA DADLDNAVEF AHHGVFYHQG QCCIAASRIF VEESIYDEFV RRSVERAKKY ILGNPLTPGV TQGPQIDKEQ YDKILDLIES GKKEGAKLEC GGGPWGNKGY FVQPTVFSNV TDEMRIAKEE IFGPVQQIMK FKSLDDVIKR ANNTFYGLSA GVFTKDIDKA ITISSALQAG TVWVNCYGVV SAQCPFGGFK MSGNGRELGE YGFHEYTEVK TVTVKISQKN S
靶标信息
ALDH1A1 belongs to the aldehyde dehydrogenases family of proteins. Aldehyde dehydrogenase is the second enzyme of the major oxidative pathway of alcohol metabolism. Two major liver isoforms of this enzyme, cytosolic and mitochondrial, can be distinguished by their electrophoretic mobilities, kinetic properties, and subcellular localizations. Most Caucasians have two major isozymes, while approximately 50% of Orientals have only the cytosolic isozyme, missing the mitochondrial isozyme. A remarkably higher frequency of acute alcohol intoxication among Orientals than among Caucasians could be related to the absence of the mitochondrial isozyme.
仅用于科研。不用于诊断过程。未经明确授权不得转售。